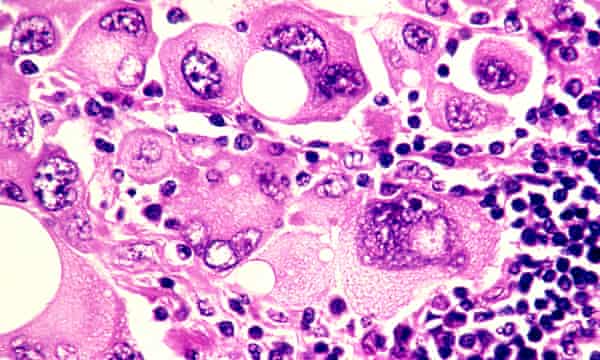

Notre consultation est presque terminée lorsque mon patient se penche en avant et dit : « Alors, docteur, pendant tout ce temps, personne n’a expliqué cela. Comment vais-je mourir exactement ? » Il a dans les 80 ans, avec une tête de cheveux enneigés et un visage bordé d’expérience. Il a refusé une deuxième série de chimiothérapie et a choisi de recevoir des soins palliatifs. Pourtant, universitaire dans l’âme, il est curieux du corps humain et aime les bonnes explications.
« Qu’avez-vous entendu ? » Je demande. « Oh, les habituelles histoires effrayantes », répond-il légèrement ; mais l’anxiété sur son visage est indubitable et je me sens soudainement protectrice envers lui.
« Voulez-vous en discuter aujourd’hui ? ». Je lui demande gentiment, me demandant s’il ne voudrait pas que sa femme soit présente.
« Comme vous pouvez le voir, je meurs d’envie de savoir », dit-il, ravi de sa propre blague.
Si vous êtes atteint d’un cancer, ou si vous vous occupez de quelqu’un qui en est atteint, c’est une question à laquelle vous avez peut-être pensé. « Comment meurt-on du cancer ? » est l’une des questions les plus fréquemment posées à Google. Pourtant, il est étonnamment rare que les patients la posent à leur oncologue. En tant que personne ayant perdu de nombreux patients et pris part à de nombreuses conversations sur la mort et le décès, je vais faire de mon mieux pour expliquer cela, mais d’abord un peu de contexte pourrait aider.
Certaines personnes ont clairement peur de ce qui pourrait être révélé si elles posent la question. D’autres veulent savoir mais sont dissuadées par leurs proches. « Quand on parle de mourir, on arrête de se battre », a admonesté une femme à son mari. Le cas d’une jeune patiente est gravé dans mon esprit. Quelques jours avant sa mort, elle m’a supplié de lui dire la vérité parce qu’elle devenait lentement confuse et que sa famille religieuse l’avait maintenue dans l’ignorance. « J’ai peur que tu sois en train de mourir », ai-je commencé, en lui tenant la main. Mais à ce moment-là, son mari est entré et, ayant entendu l’échange, il était furieux que j’aie éteint son espoir à un moment critique. Alors qu’elle s’excusait du regard, il m’a crié dessus et m’a expulsé de la pièce, puis l’a ramenée de force chez elle.
Il n’est pas étonnant qu’il y ait une réticence de la part des patients et des médecins à discuter du pronostic, mais il est prouvé qu’une communication sincère et sensible et, si nécessaire, une discussion sur la mortalité, permettent aux patients de prendre en charge leurs décisions en matière de soins de santé, de planifier leurs affaires et de s’écarter des thérapies inutilement agressives. Contrairement aux craintes populaires, les patients attestent que la conscience de la mort n’entraîne pas une plus grande tristesse, anxiété ou dépression. Elle ne précipite pas non plus la mort. Il est prouvé qu’au lendemain du décès, les membres de la famille endeuillée se disent moins anxieux et moins déprimés s’ils ont participé aux conversations sur la mort. Dans l’ensemble, l’honnêteté semble être la meilleure politique.
Les études montrent de manière inquiétante que la majorité des patients ne connaissent pas le pronostic final, soit parce qu’on ne leur a pas dit, soit parce qu’ils ont mal compris l’information. Il est quelque peu décevant de constater que les oncologues qui communiquent honnêtement sur un mauvais pronostic peuvent être moins appréciés par leur patient. Mais lorsque nous passons sous silence le pronostic, il est naturellement encore plus difficile de s’approcher de la question de savoir comment on peut mourir.
Grâce aux progrès de la médecine, de nombreux patients atteints de cancer ne meurent pas et les chiffres ne cessent de s’améliorer. Deux tiers des patients diagnostiqués avec un cancer dans le monde riche aujourd’hui survivront cinq ans et ceux qui atteignent la marque de cinq ans amélioreront leurs chances pour les cinq années suivantes, et ainsi de suite. Mais le cancer est en réalité une multitude de maladies différentes qui se comportent de manière très différente. Certains cancers, comme le cancer du côlon, lorsqu’ils sont détectés à un stade précoce, sont guérissables. Le cancer du sein précoce est hautement guérissable, mais il peut récidiver des décennies plus tard. Le cancer de la prostate métastatique, le cancer du rein et le mélanome, qui jusqu’à récemment avaient des options de traitement lamentables, sont maintenant abordés avec des thérapies de plus en plus prometteuses qui donnent des temps de survie sans précédent.
Mais la vérité qui donne à réfléchir est que le cancer avancé est incurable et bien que les traitements modernes puissent contrôler les symptômes et prolonger la survie, ils ne peuvent pas prolonger la vie indéfiniment. C’est pourquoi je pense qu’il est important pour tous ceux qui veulent savoir, comment les patients atteints de cancer meurent réellement.
« L’incapacité à prospérer » est un terme général pour un certain nombre de développements dans le cancer en phase terminale qui conduisent essentiellement à ce que quelqu’un ralentisse dans une détérioration progressive jusqu’à la mort. Le cancer est causé par une croissance désinhibée de cellules auparavant normales qui échappent habilement aux défenses habituelles de l’organisme pour se propager, ou métastaser, dans d’autres parties du corps. Lorsque le cancer touche un organe vital, sa fonction est altérée et cette altération peut entraîner la mort. Le foie et les reins éliminent les toxines et maintiennent une physiologie normale – ce sont normalement des organes de grande réserve, donc lorsqu’ils tombent en panne, la mort est imminente.
Les cellules cancéreuses libèrent une pléthore de produits chimiques qui inhibent l’appétit et affectent la digestion et l’absorption des aliments, ce qui entraîne une perte de poids progressive et donc une profonde faiblesse. La déshydratation n’est pas rare, en raison du dégoût pour les liquides ou de l’incapacité à avaler. Le manque de nutrition, d’hydratation et d’activité entraîne une perte rapide de la masse musculaire et une faiblesse. Les métastases pulmonaires sont fréquentes et peuvent provoquer un essoufflement pénible. Il est important de comprendre que les poumons (ou d’autres organes) ne s’arrêtent pas complètement de fonctionner, mais qu’ils s’épuisent lorsqu’ils sont soumis à un stress important. C’est comme pousser constamment en montée contre un poids lourd.
Les patients atteints de cancer peuvent également mourir d’une infection incontrôlée qui submerge les ressources habituelles de l’organisme. Le fait d’avoir un cancer altère l’immunité et les chimiothérapies récentes aggravent le problème en supprimant la moelle osseuse. La moelle osseuse peut être considérée comme l’usine où sont produites les cellules sanguines – sa fonction peut être altérée par la chimiothérapie ou l’infiltration de cellules cancéreuses.La mort peut survenir à la suite d’une infection grave. Une insuffisance hépatique préexistante ou une insuffisance rénale due à la déshydratation peuvent également rendre le choix des antibiotiques difficile.
Vous pouvez remarquer que les patients atteints d’un cancer impliquant leur cerveau semblent particulièrement mal en point. La plupart des cancers du cerveau proviennent d’ailleurs, comme le sein, le poumon et le rein. Les métastases cérébrales exercent leur influence de quelques façons – en provoquant des crises, une paralysie, des saignements ou des troubles du comportement. Les patients affectés par des métastases cérébrales peuvent devenir fatigués et désintéressés et devenir rapidement fragiles. Le gonflement du cerveau peut entraîner une perte progressive de conscience et la mort.
Dans certains cancers, comme celui de la prostate, du sein et du poumon, les métastases osseuses ou les changements biochimiques peuvent donner lieu à des niveaux dangereusement élevés de calcium, ce qui entraîne une réduction de la conscience et une insuffisance rénale, conduisant à la mort.
Les saignements incontrôlés, les arrêts cardiaques ou l’insuffisance respiratoire due à un gros caillot de sang se produisent – mais contrairement à la croyance populaire, la mort soudaine et catastrophique dans le cancer est rare. Et bien sûr, même les patients atteints d’un cancer avancé peuvent succomber à une crise cardiaque ou à un accident vasculaire cérébral, causes courantes de mortalité non cancéreuse dans la communauté générale.
Vous avez peut-être entendu parler du soi-disant « double effet » de l’administration de médicaments puissants comme la morphine pour la douleur cancéreuse, craignant que l’escalade des niveaux de médicaments ne précipite la mort. Mais les experts disent que les opioïdes sont essentiels pour soulager la souffrance et qu’ils ne raccourcissent généralement pas une vie déjà limitée.
Il est important d’apprécier que la mort peut se produire de plusieurs façons, alors je voulais aborder le sujet important de ce que les professionnels de la santé peuvent faire pour faciliter le processus de la mort.
Dans les endroits où de bons soins palliatifs sont intégrés, leur valeur ne peut être surestimée. Les équipes de soins palliatifs fournissent une assistance experte dans la gestion des symptômes physiques et de la détresse psychologique. Elles peuvent répondre aux questions épineuses, conseiller les membres anxieux de la famille et aider les patients à laisser un héritage, sous forme écrite ou numérique. Elles normalisent le deuil et aident à mettre en perspective un moment difficile.
Les personnes qui découvrent les soins palliatifs craignent généralement de ne pas bénéficier d’une prise en charge efficace du cancer, mais il existe de très bonnes preuves que les soins palliatifs améliorent le bien-être psychologique, la qualité de vie et, dans certains cas, l’espérance de vie. Les soins palliatifs sont relativement nouveaux dans le domaine médical, il se peut donc que vous viviez dans une région où il n’existe pas de service officiel, mais il peut y avoir des médecins locaux et des travailleurs paramédicaux formés à certains aspects de leur prestation, alors n’oubliez pas de vous renseigner.
Enfin, un mot sur la façon de demander à votre oncologue le pronostic et, par ricochet, comment vous allez mourir. Ce que vous devez savoir, c’est que dans de nombreux endroits, la formation dans ce domaine délicat de la communication est terriblement insuffisante et votre médecin peut se sentir mal à l’aise pour aborder le sujet. Mais cela ne devrait pas empêcher tout médecin d’essayer – ou au moins de vous adresser à quelqu’un qui peut vous aider.
Un pronostic précis est difficile, mais vous devez vous attendre à une estimation en termes de semaines, de mois ou d’années. Lorsqu’il s’agit de poser les questions les plus difficiles, ne vous attendez pas à ce que l’oncologue lise entre les lignes. Il s’agit de votre vie et de votre mort : vous avez droit à une opinion honnête, à une conversation continue et à des soins compatissants qui, soit dit en passant, peuvent provenir d’un grand nombre de personnes, notamment des infirmières, des travailleurs sociaux, des médecins de famille, des aumôniers et, bien sûr, de vos proches.
Il y a plus de 2 000 ans, le philosophe grec Épicure observait que l’art de bien vivre et l’art de bien mourir ne faisaient qu’un. Plus récemment, Oliver Sacks nous a rappelé ce principe alors qu’il se mourait d’un mélanome métastatique. Si nous devons mourir, il est bon de nous rappeler le rôle que nous pouvons jouer pour garantir une mort paisible.
{{topLeft}
{bottomLeft}}
{topRight}
{bottomRight}
.
{{/goalExceededMarkerPercentage}}
{{/ticker}}
{{heading}}
{{#paragraphs}}
{{.}}
{{/paragraphes}}{{texte mis en évidence}}

- Partager sur Facebook
- Partager sur Twitter
- Partager par courriel
- Partager sur LinkedIn
- Partager sur Pinterest
- Partager sur WhatsApp
- Partager sur Messenger
.